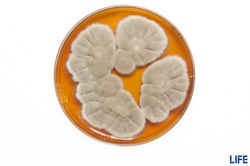

top of page
foto - video - audio
​
reinhard wilting foto
​
CVR: DK38544039
​
DK 3520 Farum
​
​
+45 30776697
Mushrooms & molds (svampe / fungi)
​
Everybody knows the mushrooms in the forests and fields, but few know that these are only the fruiting bodies of microorganisms called fungi.The group of fungi also includes many species that do not form mushrooms but form thin layer of green mold on old food. Fungi have an important role in nature in decomposing biological material, like starch, cellulose and even wood. The photos below show common fungi in Denmark.
​
​
![]() | ![]() | ![]() |
|---|---|---|
![]() | ![]() | ![]() |
![]() | ![]() | ![]() |
![]() | ![]() | ![]() |
![]() | ![]() | ![]() |
![]() | ![]() | ![]() |
![]() | ![]() | ![]() |
![]() |
-> Hvis du interesserer dig mere for svampe kan Henning Knudsens svampebøger varmt anbefales.
Some produce dyes which have been used for centuries to stain wool and cotton. Baker´s yeast is used for baking bread and fermenting wine and beer. Many species, like Penicillium, produce antibiotics. Aspergillus oryzae has been used for hundreds of years to ferment soy sauce form soy beans.
Fungi and bacteria are important sources of enzymes which are used in large scales to replace chemicals and save energy in industrial processes.
​
In the videos LEARNING FROM NATURE and EARTHRISE - ARTIC ENZYMES my colleagues Sara Landvik and Mikako Sasa, mycologists at Novozymes, explains fungi in an easy way.

The depth of field of macro photos is extremely small, even if you close the aperture. Either you take quite flat photos as above or you use a quite advanced technique: To show the three dimensional shape of the fungi I took 20 to 50 photos with changing focus and used focus stacking software to generate a photo that is sharp from end to end. The bricks are not the fungus itself, but blocks of agar that have been cut out with the fungus from another plate to transfer the fungus to "fresh food" and keep it alive.
![]() | ![]() | ![]() |
|---|---|---|
![]() | ![]() | ![]() |
![]() | ![]() | ![]() |
![]() | ![]() | ![]() |
![]() | ![]() |
In these close up on the right the threats ("hyphe") of the fungus become visible. They grown at the tips and cover the surface of the agar plate and the square agar block. The fungus spread forms flower-like structures . They contain the orange pigmented spores, which are the seed of the fungus. The wind carries the spores to new locations. If the conditions are suitable, a new fungus grows out pf the spore.

What you see below is not modern art, but fungi grown in the laboratory on so called agar plates.
​
For updating the internal photo stock at Novozymes the mycology team grew a selection of fungi for a couple of days on agar plates until they started to produce pigments and spores. For me as microbiologist, who stopped the lab several years ago, this was a great opportunity to put on the lab coat again and mount a macro lense on my camera for this portrait session in micro-scale.
​
​
​
![]() | ![]() | ![]() |
|---|---|---|
![]() | ![]() | ![]() |
![]() | ![]() | ![]() |
![]() | ![]() | ![]() |
![]() | ![]() | ![]() |
![]() |
publication with kind permission of Novozymes and Novo Nordisk Fond;
photos: Reinhard Wilting
In addition you see a set of fungi that grow in Denmark. The photos of will be used in a LIFE project at Danish schools where the children can identify mushrooms they find in nature. The LIFE project is a Novo Nordisk Fond initiative that is supported by the microbiologists at Novozymes.
​
Thanks to Sara Landvik, Mikako Sasa and May-Britt for the assistance.
​


bottom of page